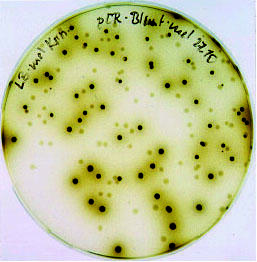
Biocatalytic oxyfunctionalization processes for pharmaceutical intermediates

Biocatalytic oxyfunctionalization processes for pharmaceutical intermediates
The project focused on the development of electroenzymatic approaches for the production of oxy-functionalized hydrocarbons.
These compounds are key intermediates in pharmaceutical industries. Developed solutions contribute to key problems of oxidoreduction biocatalysis like in vitro cofactor regeneration and implement process design, interdisciplinary and innovative aspects of rational and evolutive biocatalyst design, and screening of natural diversity.
Perfect biocatalysts
The cooperation partners developed and validated screening systems by direct oxygenase evolution and discovered novel promising oxygenases for hydrogen-carbon functionalization. The first directed evolution approach for an epoxygenase reaction represents a breakthrough to tailor these important biocatalysts to industrial demands in bioprocesses. Combining the novel oxygenases, advanced mutagenesis technologies (SeSaM), rational design tools, and developed bioelectrochemical process technology a platform has been established to push oxygenation biocatalysis towards industrial applications. This technology platform offers the opportunity for the production of chiral compounds in environmentally friendly processes.